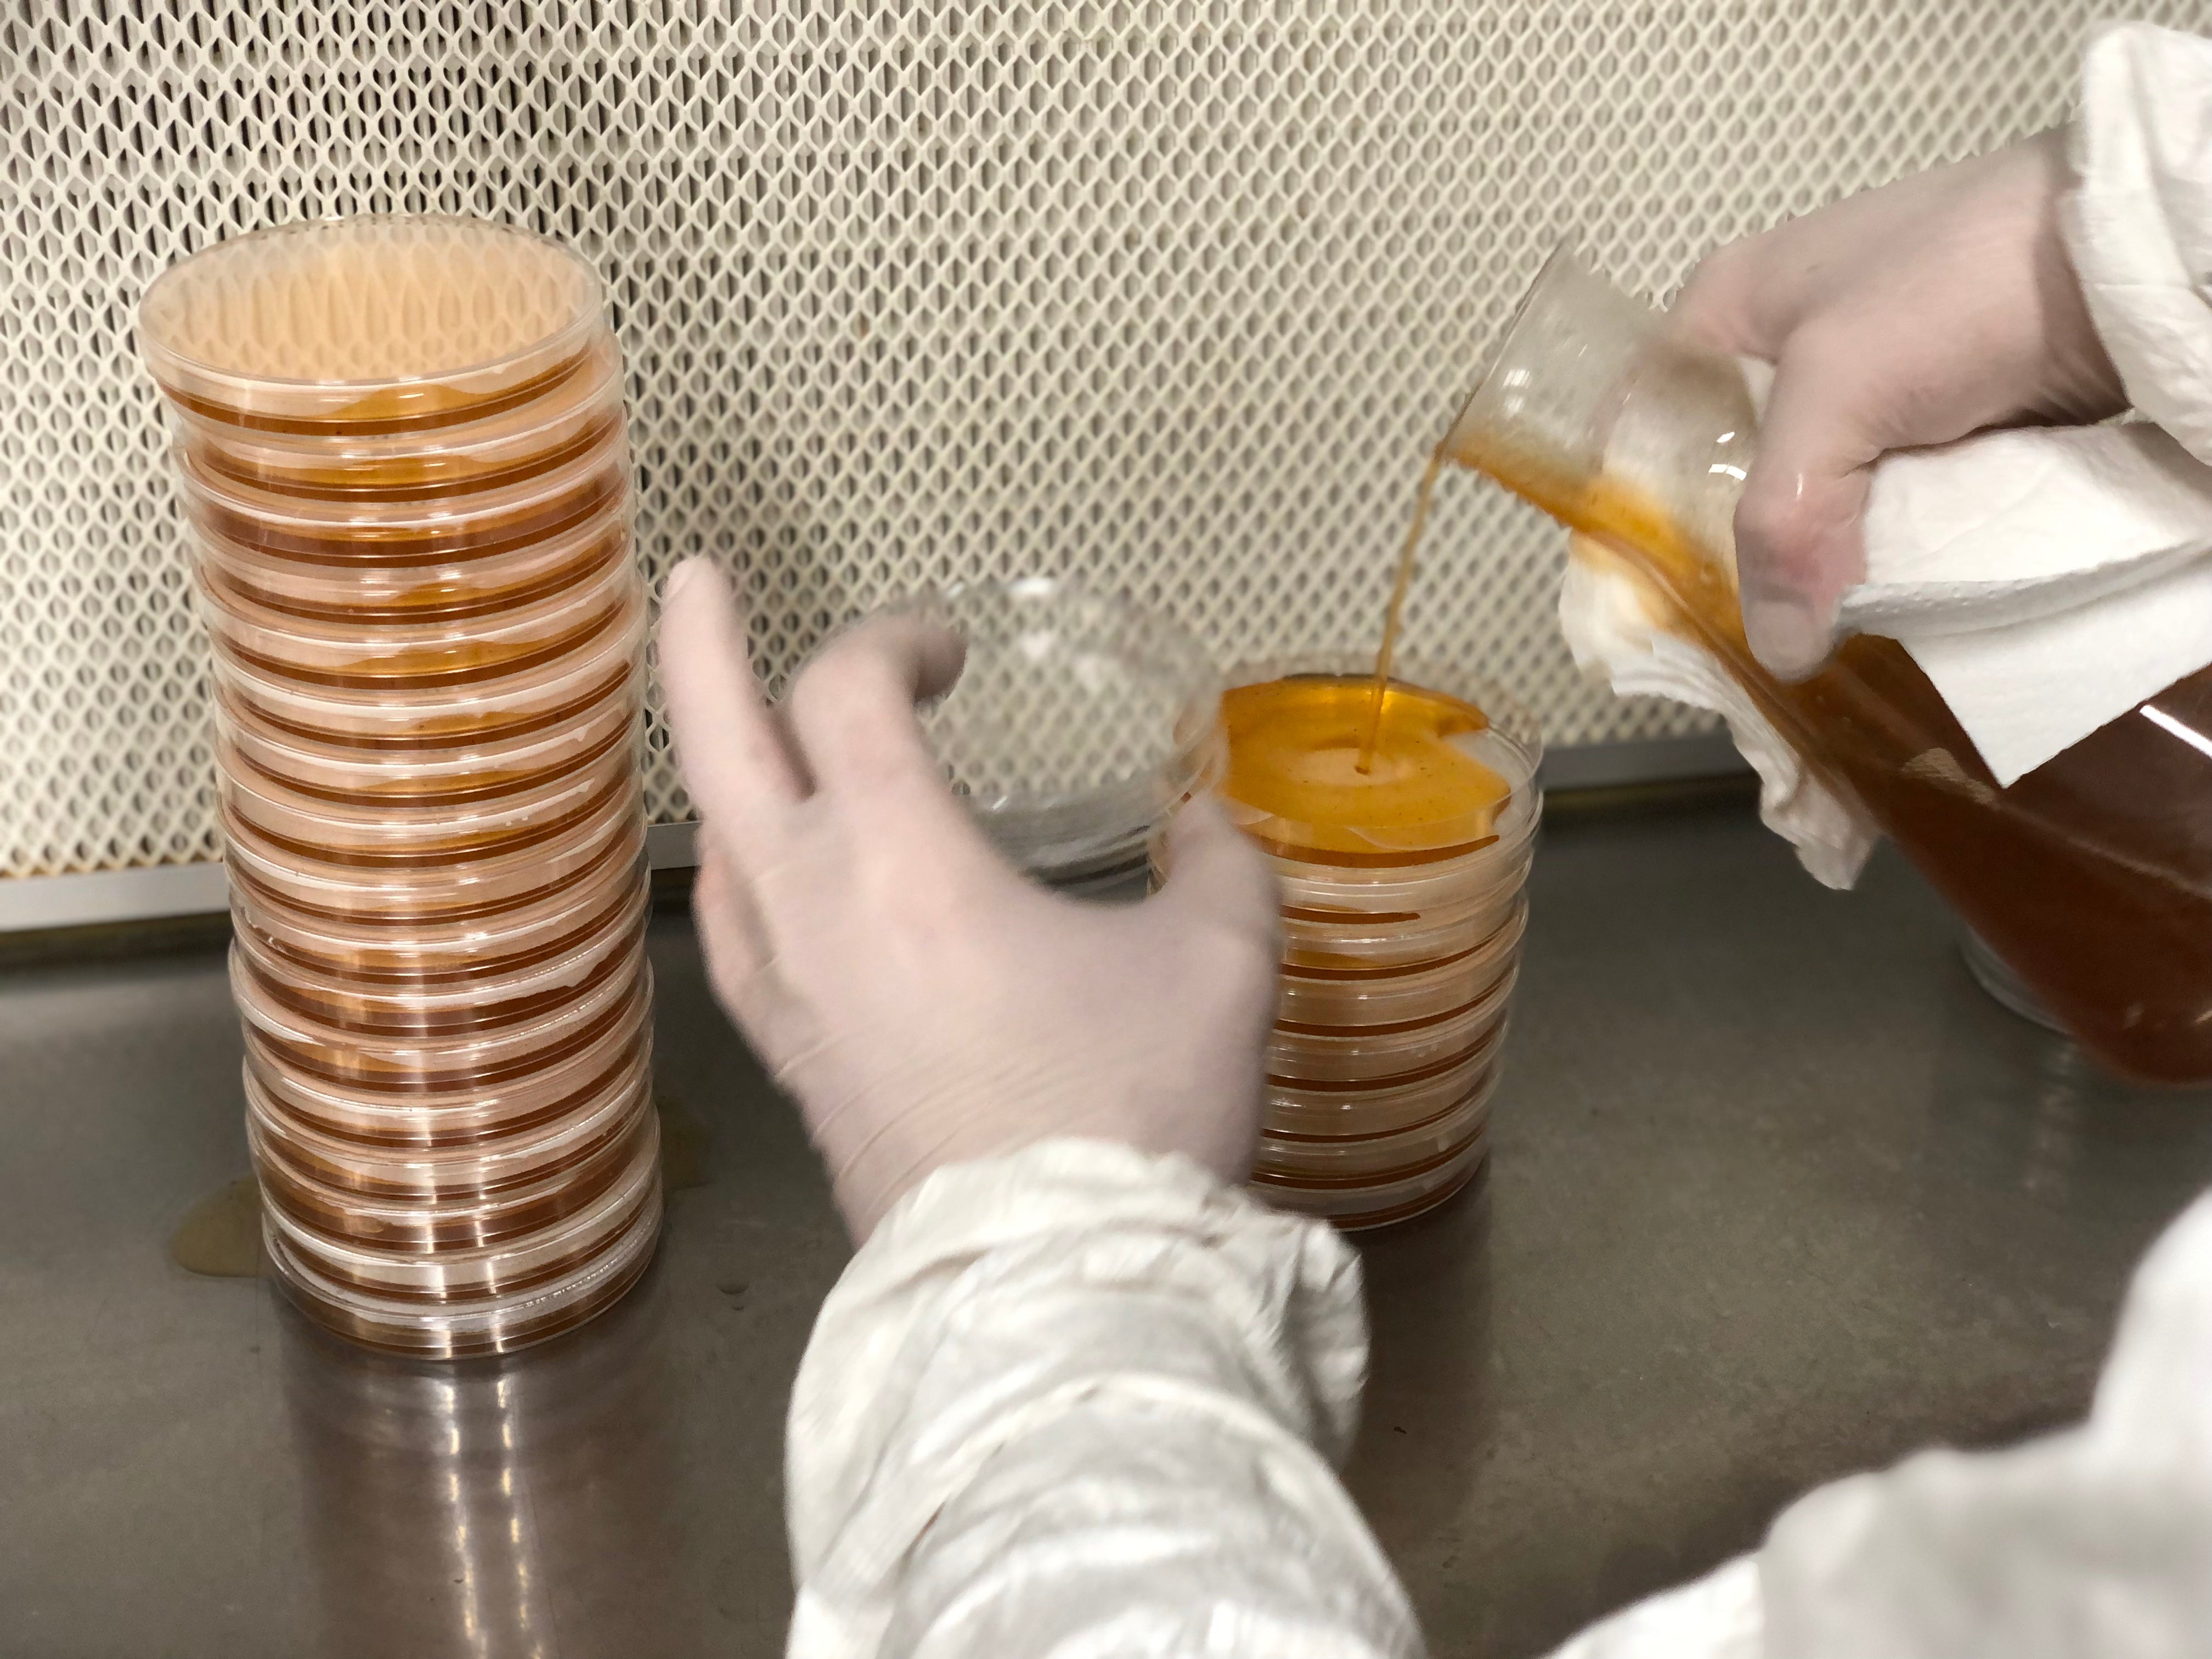
coulagede boites de pétri

Milieux de culture pour boîtes de pétri
- 🧫 MILIEUX DE CULTURE PRÉ-REMPLIS : Idéaux pour cultures fongiques et clonage, avec gélose stérilisée.
- 💎 AVANTAGES : Facilité d'usage et réduction de risque de contamination.
- 🔬 DIFFÉRENTS MILIEUX :
- Milieu "MPA" (Malt, Peptone, Agar-agar) : Multiplication optimale de la plupart des mycéliums.
- Milieu "Sabouraud + Antibiotique" : Sélectif pour limiter les bactéries, idéal pour clonage et germination des spores.
- 🌍 AGAR-AGAR SÉPARÉ : Disponible pour créer vos propres mélanges et enrichir vos milieux de culture.
- 📏 UTILISATION : Délayez 47 g de milieu dans 1 litre d'eau chaude, stérilisez à 121°C pendant 20-30 minutes, laissez refroidir, puis répartissez dans les boîtes.
Découvrez nos milieux de culture pour la réalisation de vos boîtes de pétri :
-
Milieu "MEA+" (Malt Extract, Agar-agar, Peptone) :
Milieu nutritif riche, adapté à la culture de la majorité des mycéliums. Il favorise également le développement des bactéries, ce qui en fait un bon choix pour tester la pureté de l’air ou des échantillons (tests de contamination). - Milieu "Sabouraud + Antibiotique" :
Enrichi d’un antibiotique (chloramphénicol), ce milieu limite la croissance bactérienne et devient très sélectif. Il est idéal pour des manipulations sensibles comme le clonage de champignons sauvages ou la germination de spores, surtout en conditions non stériles. La croissance mycélienne peut toutefois y être un peu plus lente qu’avec un milieu comme MEA+.
Ces milieux sont conçus pour être utilisés avec nos boîtes de pétri stériles et nos films étirables.
Utilisation :
- Délayez le sachet de 47 g dans 1 litre d'eau chaude (de préférence de l'eau distillée ou déminéralisée). Homogénéisez.
- Stérilisez à 121°C (15 PSI) pendant 20-30 minutes.
- Laissez refroidir jusqu'à 45-50°C, puis répartissez dans les boîtes de pétri.
Le refroidissement et la répartition de la gélose dans les boîtes de pétri doivent se faire dans un environnement stérile (hotte à flux laminaire, bec bunsen ou autre technique) pour éviter les contaminations.
Si vous versez le liquide trop chaud dans les boîtes de pétri, de la condensation peut se former sur les couvercles. Si vous attendez trop longtemps pour le refroidissement, le mélange risque de se solidifier.